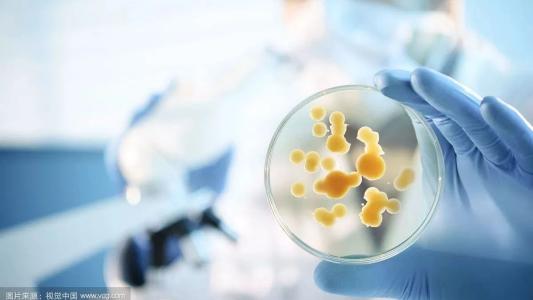
武穴市有哪些做4-硝基苯胺生產(chǎn)廠家有哪些

地址:湖北省武穴市馬口醫(yī)藥產(chǎn)業(yè)園
聯(lián)系人:郭天慶
電話:18955189847
咨詢電話:
郵箱:
網(wǎng)址:http://www.jinchuangbobio.com/
2-氯煙酸在化肥層面,可用以生成滅草劑煙嘧磺隆、吡氟酰草胺、農(nóng)藥殺菌劑啶酰菌胺等。
不一樣水平腎病綜合癥者一次內(nèi)服400mg加替沙星,隨腎臟功能降低的水平不一樣加替沙星的表觀總清除率(CI/F)相對(duì)應(yīng)減少,曲線圖下總面積(AUC)相對(duì)應(yīng)提升。輕中度腎病綜合癥(肌酐清除率30~40ml/min)患者加替沙星清除率降低57%,中重度(肌酐清除率<30ml/min)患者則降低77%。
吡喹酮膏劑是全透明的半固態(tài),釋藥速率較快,擦抹肌膚可以產(chǎn)生全透明的塑料薄膜,可水清洗,對(duì)蠕形螨感柒的酒渣型皮膚疾病等方便使用。

2-氟煙酸是一種關(guān)鍵的化肥和醫(yī)藥中間體,從容易得到便宜原材料在可控性反映標(biāo)準(zhǔn)下高成品率制取2-氯煙酸是銷售市場(chǎng)急需解決,報(bào)導(dǎo)了一條運(yùn)用關(guān)環(huán)反映生成2-氟煙酸的新技術(shù)新工藝.以固態(tài)光氣與N,N-二甲基甲酰胺為起止原材料,反映轉(zhuǎn)化成Vilsmeier鹽與甲基丙烯酸酯正丁醚轉(zhuǎn)化成化工中間體2,化工中間體2與二甲胺反映轉(zhuǎn)化成銨基化學(xué)物質(zhì)3,進(jìn)一步與磺酸基乙酸丁酯反映可獲得2-磺酸基-5-二甲胺基-2,4-二烯-戊酸乙酯4,4在氯化氫乙醇溶液中關(guān)環(huán)獲得2-氯煙酸乙酯,水解反應(yīng)獲得物質(zhì)2-氯煙酸.對(duì)化工中間體3,4和5的反映標(biāo)準(zhǔn)開展了提升,生成總成品率63.4%,商品純凈度達(dá)99.6%.明確了該加工工藝反映的最好反映標(biāo)準(zhǔn),生成標(biāo)準(zhǔn)柔和,合適工業(yè)生產(chǎn).
生殖系統(tǒng)毒副作用: 對(duì)大白鼠經(jīng)口給與使用量達(dá)到200mg/kg(以每日曝露量(AUC)計(jì),和人較大 強(qiáng)烈推薦量等效電路),對(duì)大白鼠生育能力和生殖系統(tǒng)無副作用。大白鼠和新西蘭兔經(jīng)口給與使用量各自達(dá)150mg/kg和50mg/kg(以AUC計(jì),約為人正直較大 強(qiáng)烈推薦使用量的0.7和1.9),末見生姿畸胎功效。
本品關(guān)鍵根據(jù)5-HT樣功效使寄主身體血吸蟲、絳蟲造成經(jīng)攣麻木掉下來,對(duì)大部分絳蟲若蟲和未熟蟲體都是有不錯(cuò)實(shí)際效果,與此同時(shí)能危害蟲體心肌細(xì)胞內(nèi)鈉離子滲透性,使鈉離子內(nèi)流提升,抑止肌漿網(wǎng)鈣泵的再攝入,蟲體心肌細(xì)胞內(nèi)鈉離子成分暴增,使蟲體麻木掉下來。

第二代氟喹諾酮,在抗菌譜層面有一定的擴(kuò)張,對(duì)腸桿菌屬、枸櫞酸鏈球菌、綠膿桿菌、沙雷鏈球菌也是有一定抑菌功效。吡哌酸是中國(guó)關(guān)鍵運(yùn)用種類。除此之外還有新惡酸和甲氧惡喹酸,在海外有生產(chǎn)制造。
喹啉羧基乙酯CAS號(hào):112811-71-9化學(xué)式: C16H15F2NO4 外型 淺黃色至白色粉末
10.本品在配置供靜滴用1ml2mg濃度值的靜滴液時(shí),為確保滴注液與滲透壓等張,不適合選用一般注射用水。

加替沙星關(guān)鍵經(jīng)腎臟功能排出來,肌酐清除率<40ml/min病人,包含血透和長(zhǎng)期性腹膜透析病人,應(yīng)調(diào)節(jié)本品的使用量。血透患者應(yīng)在每一次血透完畢后服藥。
吡喹酮醫(yī)治吸血蟲病盡管擁有 使用量小、療程短、副作用輕的優(yōu)勢(shì),但并不是沒有副作用。2日治療法盡管副作用較少,但服藥后仍會(huì)出現(xiàn)頭暈?zāi)垦?、困乏、流汗、頭疼、失眠癥、全身肌肉晃動(dòng)、夢(mèng)多、眼顫、肢端發(fā)麻和輕微拉肚子等不良反應(yīng),極少數(shù)病人還很有可能發(fā)生中毒性肝炎或引起神智不清。多飲水能夠 稀釋液藥品成分,加速新陳代謝,促進(jìn)有有害物質(zhì)物從身體盡早排出來。
2-氯煙酸甲酯是化合物,化學(xué)式是C7H6ClNO2。

7、現(xiàn)有患者在接納一些喹諾酮藥品后產(chǎn)生光毒副作用反映。雖在小動(dòng)物實(shí)驗(yàn)和臨床研究中,末見本品在強(qiáng)烈推薦使用量水準(zhǔn)產(chǎn)生光毒副作用。但為確保診療順利執(zhí)行,應(yīng)防止過多陽(yáng)光或人力紫外線照射。假如發(fā)生皮膚曬傷樣反映或產(chǎn)生肌膚危害,應(yīng)立即就醫(yī)。
吡喹酮對(duì)蟲體能起二種關(guān)鍵藥用價(jià)值:(1)蟲體全身肌肉產(chǎn)生強(qiáng)直性收攏而造成經(jīng)攣麻木。血吸蟲觸碰較低濃度的吡喹酮后僅20秒鐘蟲體支撐力即提高,藥濃度值達(dá)1mg/L之上時(shí),蟲體瞬即明顯肌肉萎縮。蟲體牽張反射很有可能與吡喹酮提升蟲體細(xì)胞質(zhì)的滲透性,使體細(xì)胞bai鈉離子缺失相關(guān)。
藥物是一樣的,功效還需要看生產(chǎn)商,我國(guó)如今生產(chǎn)制造抗菌素的生產(chǎn)廠家比比皆是,一些大廠家生產(chǎn)的藥品安全不錯(cuò),功效高,副作用發(fā)病率低,而一些小型加工廠盡管也根據(jù)gmp驗(yàn)證,但因?yàn)闄C(jī)器設(shè)備加工工藝落伍等緣故,生產(chǎn)制造出去的藥物功效差,且非常容易產(chǎn)生副作用.

甘肅省某公司總投資1.五億元氯代胺、2-氯煙酸新項(xiàng)目配套設(shè)施廢水處理設(shè)備
能夠 異喹啉為原材料,經(jīng)Reissert反映,在l位引進(jìn)磺酸基和氮上苯甲乙?;?隨后酯化,與此同時(shí)苯甲酰基遷移到主鏈的羥基上,再在環(huán)上的羥基上引進(jìn)氯酰胺基,隨后環(huán)合、水解反應(yīng)、環(huán)己甲?;眠拎?[1]??。
根據(jù)此,必須對(duì)于傳統(tǒng)式的加替沙星羧基的生成方式造成很多的強(qiáng)酸堿性污水的難題,給予一種加替沙星羧基以及生成方式。

加替沙星在世界各國(guó)臨床研究中的副作用為惡心想吐,陰道炎癥,拉肚子,頭疼、暈眩。發(fā)病率較低的藥品有關(guān)不良反應(yīng)包含:全身上下反映:超敏反應(yīng),寒顫,發(fā)燙,背疼和胸口痛。
加替沙星對(duì)孕媽媽、授乳女性的功效和安全系數(shù)并未創(chuàng)建。孕媽媽和授乳女性應(yīng)用本品應(yīng)慎重,僅有在應(yīng)用本品所獲利處超過對(duì)胎寶寶和寶寶很有可能的危險(xiǎn)因素時(shí),才可考慮到。
中樞神經(jīng)系統(tǒng):夢(mèng)多,失眠癥,覺得出現(xiàn)異常,震顛,毛細(xì)血管擴(kuò)張,暈眩。呼吸道:呼吸不暢,咽喉炎。肌膚及肌膚皮下組織:疹子,流汗。

9.本品務(wù)必選用無菌檢測(cè)方式稀釋液和配置。在稀釋液和應(yīng)用前務(wù)必查詢有沒有顆粒內(nèi)溶物,一旦發(fā)覺人眼由此可見的顆粒物則應(yīng)棄去無需。本品僅作一次應(yīng)用,故配置后未用完一部分應(yīng)棄去。禁止將別的中藥制劑添加含本品的瓶中靜滴,也不能將別的靜脈血管中藥制劑與本品經(jīng)同一靜脈注射安全通道應(yīng)用。假如同一靜脈注射安全通道用以滴注不一樣的藥品,在應(yīng)用本品前后左右務(wù)必用與本品和別的藥品相溶的水溶液清洗安全通道。假如本品與別的藥品協(xié)同應(yīng)用,則務(wù)必按本品和該共用藥品強(qiáng)烈推薦使用量和方式各自分離給藥。
加替沙星為8-叔丁基氟喹諾酮類外消旋體化學(xué)物質(zhì),身體之外具備廣譜性的抗革蘭陰性和陽(yáng)性微生物菌種的活力,其R-和S-對(duì)映體抑菌活力同樣。本品的抑菌功效是根據(jù)抑止病菌的DNA轉(zhuǎn)動(dòng)酶和拓?fù)洚悩?gòu)酶IV,進(jìn)而抑止病菌DNA的拷貝、基因表達(dá)和修復(fù)。
相近的結(jié)果在其他氟喹諾酮的藥品也由此可見,這可能是由濃度較高的下本品對(duì)真核生物的II型DNA拓?fù)洚悩?gòu)酶的抑制效果而致。本品經(jīng)口和靜脈血管給藥的小白鼠微核試驗(yàn)、大白鼠經(jīng)口給藥的體細(xì)胞細(xì)胞生物學(xué)實(shí)驗(yàn)、大白鼠經(jīng)口給藥的DNA修復(fù)實(shí)驗(yàn)結(jié)果均為呈陰性。
1、本品主冶由敏感菌造成的禽畜呼吸道、泌尿男科泌尿系統(tǒng)、肌膚皮下組織、消化道等病癥,如禽的大腸桿菌病、沙門氏病、感染性鼻竇炎,雞奇特沙門菌病、鏈球菌病,鴨疫巴氏桿菌病,禽霍亂、漫性呼吸系統(tǒng)病,豬氣喘病,豬仔黃、赤痢,仔豬副傷寒,牛感染性胸膜增厚肺部感染、牛出敗,?;【“Y,牛流行性感冒拉肚子,羊羔病癥、感染性腸胃炎。
2000年荷蘭也干了一項(xiàng)實(shí)驗(yàn),倆位生物學(xué)家在一年多的時(shí)間內(nèi),機(jī)構(gòu)280位60?7九歲的女士健康老人,每日服食50mgDHEA。一年后他們的肌膚廣泛越來越光潔而滋養(yǎng),人體骨骼提高,男性性功能改進(jìn)。這種科學(xué)研究的結(jié)果的確是很振奮人心的,也促進(jìn)了防衰老工作的發(fā)展趨勢(shì)。
除此之外,吡喹酮還能造成原發(fā)性轉(zhuǎn)變 ,使蟲體表膜去極化,表皮層堿性磷酸酶活力顯著降低,導(dǎo)致葡萄糖水的攝入受抑止,內(nèi)源糖元枯竭。吡喹酮還能抑制蟲體核苷酸與蛋白的生成

加替沙星為8-甲氧氟喹諾酮類外消旋化學(xué)物質(zhì),身體之外具備應(yīng)譜的抗革蘭氏陽(yáng)性菌陰性和陽(yáng)性微生物菌種的活力,其R-和S-對(duì)映體抑菌活力同樣。本品抑菌功效是根據(jù)抑止病菌的DNA轉(zhuǎn)動(dòng)酶和拓?fù)洚悩?gòu)酶IV,進(jìn)而抑止病菌DNA復(fù)制、基因表達(dá)和修復(fù)。
3.牛乳、碳酸氫鈣、西咪替丁、氨茶堿、法華令、優(yōu)降糖或咪達(dá)唑侖與本品與此同時(shí)服食末見產(chǎn)生相互影響。
2.革蘭氏陽(yáng)性菌陰性菌:大腸埃希菌、流行性感冒和副流感嗜血桿菌、肺部感染克雷伯桿菌、卡他莫拉菌、淋病奈瑟菌、奇特沙門菌。3.別的微生物菌種:肺炎衣原體、嗜肺性戰(zhàn)隊(duì)鏈球菌、支原體肺炎。

據(jù)立木商務(wù)咨詢公布的《我國(guó)2-氯煙酸市場(chǎng)調(diào)查與項(xiàng)目投資發(fā)展戰(zhàn)略匯報(bào)(2019版)》表明:2-氯煙酸是藥業(yè)和化肥化工中間體,在化肥層面,可用以生成滅草劑煙嘧磺隆、吡氟酰草胺、農(nóng)藥殺菌劑啶酰菌胺等,在藥業(yè)層面,可用以生成抗艾滋病藥奈韋拉平、抗抑郁藥物米氮平、抗病毒的藥普拉洛芬、抗感染止痛藥尼氟滅酸和煙甲滅酸等。